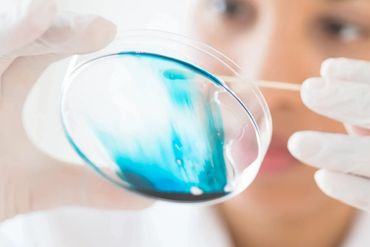

Signed in as:
filler@godaddy.com
Signed in as:
filler@godaddy.com


At SCI CRO SERVICES™, our mission is to advance pharmaceutical research and development to improve healthcare outcomes for all. We believe in the power of collaboration and innovation.

Our team of experienced scientists, industry professionals and clinician partners are dedicated to finding solutions to some of the most pressing medical challenges of our time. We bring a diverse range of expertise and perspectives to every project we undertake.

At SCI CRO SERVICES, we take a data-driven approach to pharmaceutical research and development. We leverage the latest technologies and methodologies to ensure that our projects are efficient, effective, impactful. SCI CRO™ scientists specialize in lead selection and optimization with a focus on improving efficacy, pharmacokinetics and safety.



We are a team of researchers and developers focused on discovering breakthroughs in medical science. Our mission is to improve the lives of patients by developing innovative treatments and technologies. Welcome to our website, where you can learn more about our latest projects and achievements.

Copyright © 2008-2024 Jonas Moses - All Rights Reserved.
Powered by You!
We use cookies to analyze website traffic and optimize your website experience. By accepting our use of cookies, your data will be aggregated with all other user data.